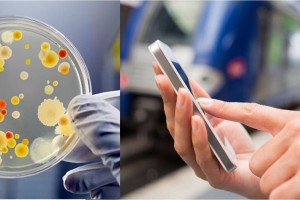

মাত্র ৩০ সেকেন্ডে ব্লাড গ্রুপ টেস্ট পদ্ধতি উদ্ভাবন

বিজ্ঞান-প্রযুক্তি ডেস্ক: চীনের থার্ড মিলিটারি মেডিক্যাল ইউনিভার্সিটি মাত্র ৩০ সেকেন্ডে একজন রোগীর ব্লাড টাইপ বের করার পদ্ধতি উদ্ভাবন করেছেন। একটি রঞ্জিত কাগজের টুকরো ব্যবহার করা হয় এক্ষেত্রে। বর্তমানে ব্যবহৃত উপায়গুলোর চাইতে নতুন এই উপায়টি অনেক কম সময় লাগে এবং এতে খরচটাও হয় কম। এতে তুলনামূলকভাবে দরিদ্র দেশগুলো উপকৃত হবে বলে আশা করা হচ্ছে। গর্ভবতী নারীদের ক্ষেত্রে, রক্ত দান এবং বোন […]
» Read more